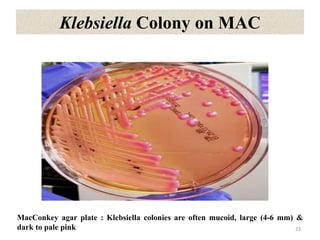
Klebsiella Colony on MAC
23
MacConkey agar plate : Klebsiella colonies are often mucoid, large (4-6 mm) &
dark to pale pink
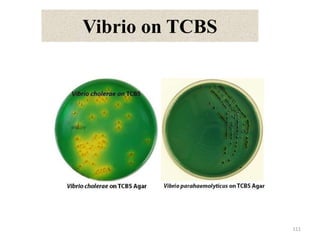
Vibrio on TCBS
111

This document provides information on the family Enterobacteriaceae. It discusses several important genera within the family including Escherichia, Salmonella, Shigella, Klebsiella, Citrobacter, Enterobacter, and their characteristics. It describes how members of Enterobacteriaceae are Gram-negative, facultative anaerobes that ferment glucose. It also outlines several virulence factors and how different genera can cause diseases like urinary tract infections, gastrointestinal illnesses, and sepsis. Laboratory identification and biochemical testing results for isolates of these bacteria are also summarized.